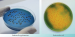
Лактозный ТТХ агар с тергитолом 7

Лактозный ТТХ агар с тергитолом 7
Питательный агар для обнаружения и учета E.coli и колиформных бактерий сухой
Для обнаружения и учета E.coli и колиформных бактерий при проведении бактериологических исследований.
Данный продукт имеет Регистрационное Удостоверение.
Срок годности 2 года.
Фасовка 250г для приготовления 7,7 л среды.
- Стерильность: -
- Форма выпуска: Порошок
- Упаковка: 250 г
- Документы: Регистрационное Удостоверение